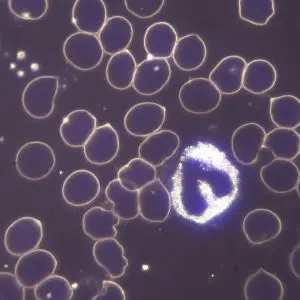
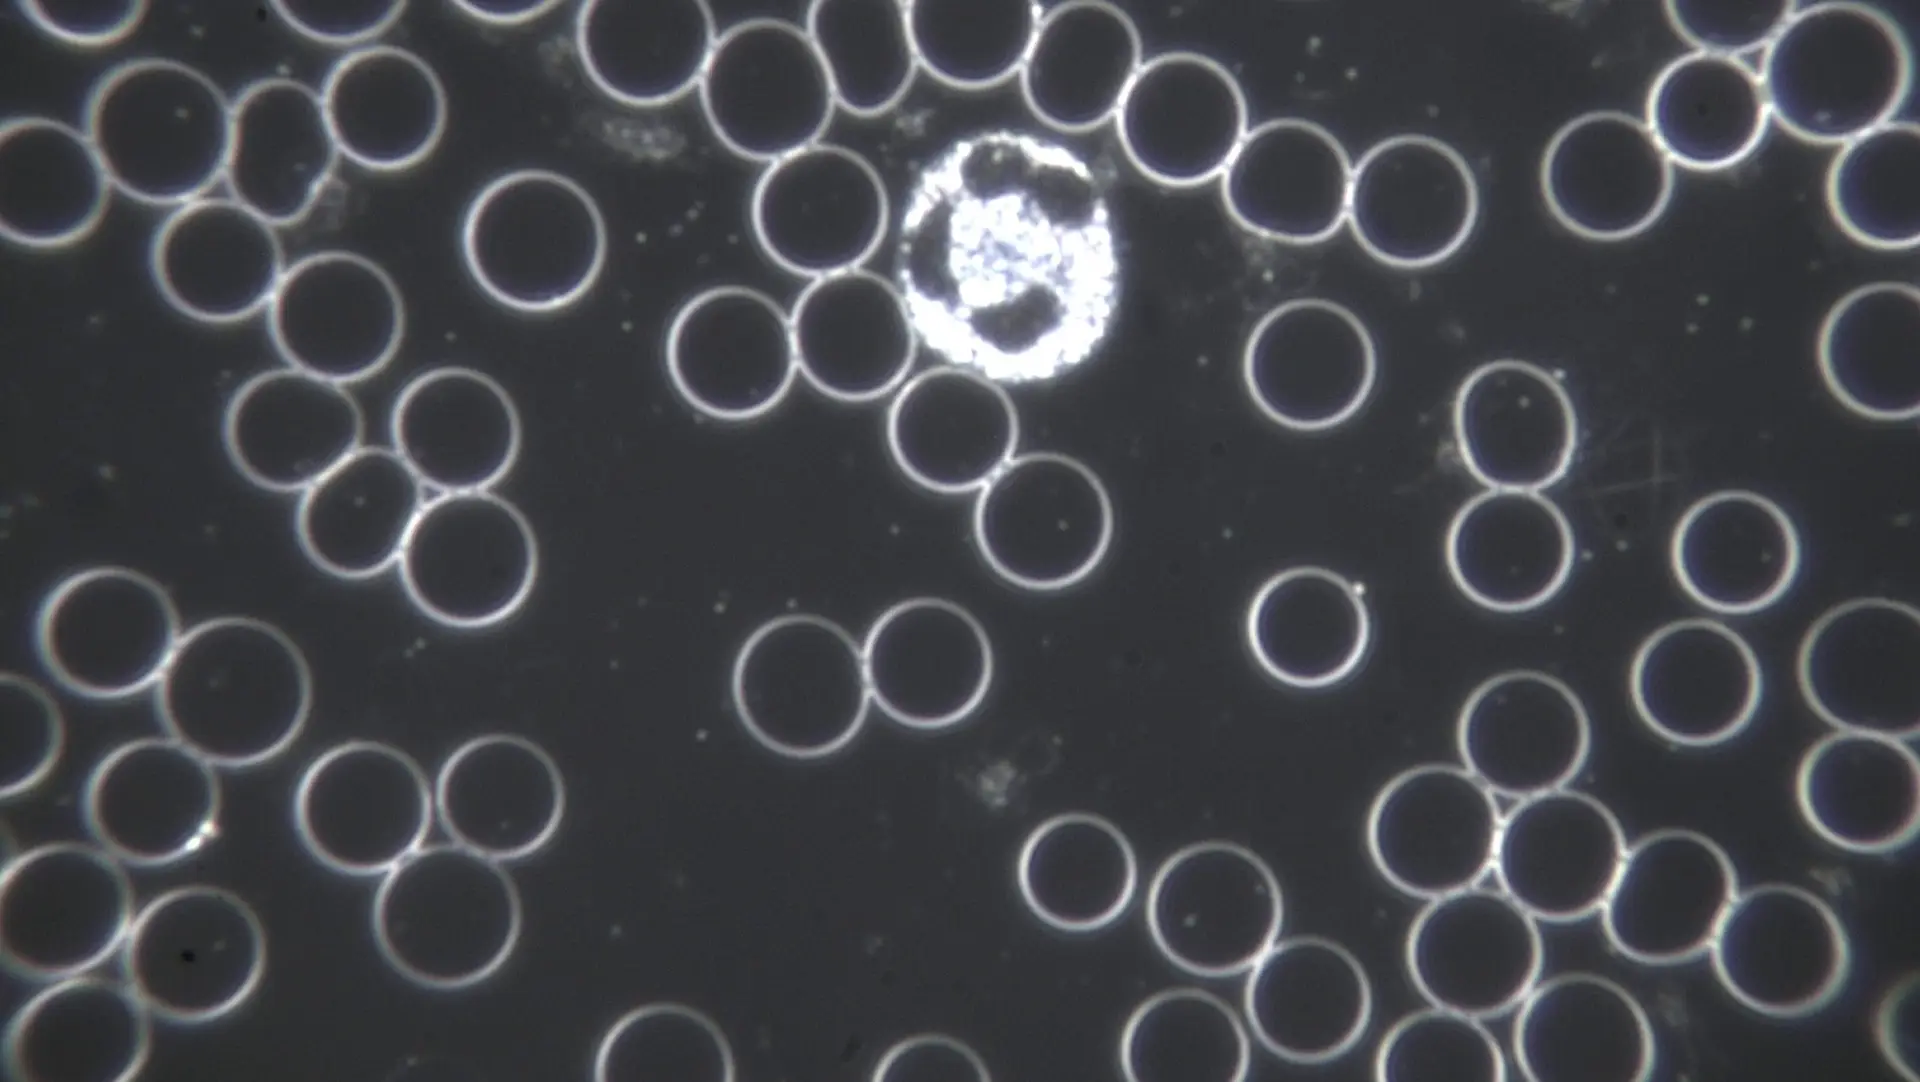
rote und weiße Blutkörperchen

Dunkelfeldmikroskopie
Vitalblutanalyse
Bei der Dunkelfeldmikroskopie liefert ein kleiner Bluttropfen aus dem Finger oder Ohrläppchen Information über die körperliche Gesamtsituation. Der Bluttropfen wird unmittelbar nach der Entnahme mittels eines speziellen Mikroskops, des Dunkelfeldmikroskops, betrachtet.
Dieses Mikroskop zählt zu den Lichtmikroskopen, deren Vorteil (im Gegensatz zu Elektronenmikroskopen) darin besteht, dass sie die Betrachtung lebender Zellen ermöglichen.
Im noch vitalen Blut sieht man die roten und weißen Blutkörperchen, Blutplättchen, Bakterien, Parasiten, Schadstoffe, Stoffwechselabfallprodukte, kristalline Strukturen, … Die verschiedenen Erscheinungen im Blutplasma sowie der Aufbau und die Funktionsweise der Blutkörperchen geben Auskunft über das innere Milieu, das im Menschen vorliegt.
Schon in den 1870er Jahren prägte der französische Physiologe Claude Bernard das berühmte Zitat: „Der Keim ist nichts, das Milieu ist alles.“ Ist das innere Milieu gestört, kann es zu Gesundheitsstörungen kommen. Ziel ist also ein gesundes inneres Milieu.

Der Begründer der Dunkelfeldmikroskopie, Prof. Dr. Günter Enderlein, entdeckte unter dem Dunkelfeldmikroskop neue Bestandteile des Blutplasmas, die sogenannten Symbionten. Er stellte im Rahmen seiner Forschungen fest, dass sich diese Symbionten pathogen, also Krankheiten verursachend, entwickeln können.
Diese krankmachende Entwicklung erfolgt durch Milieuveränderung, wie z.B. Änderungen des pH-Wertes infolge von Maßnahmen unserer Zivilisation (falsche Ernährungsweise, Umweltgifte, usw.). Mit anderen Worten: Krankheit bedeutet nach Enderlein immer eine Störung des Milieus.
Die Vitalblutanalyse mittels Dunkelfeldmikroskopie ist bis heute wissenschaftlich nicht anerkannt. Daher gibt es keine internationalen Standards, sondern sie beruht vor allem auf der Erfahrung des Therapeuten.
Beispiele